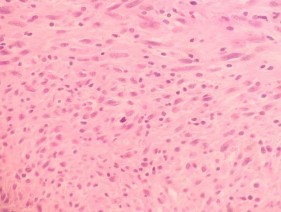
HE x 100 Thành phần u biệt hóa cao với các tế bào u có không bào rộng nhân ở 8

- Số lượng u: ……….. 1 khối 2 - 3 khối > 3 khối
- Kích thước u 1 :..................mm < 5cm 5 – 10 cm > 10cm
- Kích thước u 2 :..................mm < 5cm 5 – 10 cm > 10cm
- Kích thước u 3 :..................mm < 5cm 5 – 10 cm > 10cm
- Vị trí: Dạ dày Tá tràng Ruột non Đại tràng Trực tràng
Vị trí khác...............................................................................................
- Huyết khối tĩnh mạch cửa: Không Có Không mô tả
- Hạch ổ bụng: Không Có Không mô tả
- Các bất thường khác trên siêu âm bụng ....................................................................
D5. Chụp lưu thông ruột: Không làm
Có làm thấy u Có làm không thấy u
D6. Chụp CT: Không làm
Có làm thấy u Có làm không thấy u
- Kết luận chụp CT:
- Dịch ổ bụng: Không Có ít có vừa nhiều
- Kích thước: ghi rõ..................mm < 5 cm 5 – 10 cm > 10cm
- Số lượng: ghi rõ số lượng ……….. 1 khối 2 - 3 khối > 3 khối
- Vị trí: Dạ dày Tá tràng Ruột non Đại tràng Trực tràng
Vị trí khác: ...................................................................................................
- Tình chất trên CT: Tăng tỉ trọng Giảm Đồng Hỗn hợp
Hoại tử............................... Bắt thuốc.............................
- Huyết khối tĩnh mạch cửa: Không Có
- Hạch ổ bụng: Không Có
- Các bất thường khác:………………...........................................................................
D7. Chụp MRI: Không làm
Có làm thấy u Có làm không thấy u
- Kết luận chụp MRI:
- Dịch ổ bụng: Không Có ít có vừa nhiều
- Kích thước: ghi rõ..................mm < 5 cm 5 – 10 cm > 10cm
- Số lượng: ghi rõ số lượng ……….. 1 khối 2 - 3 khối > 3 khối
- Vị trí: Dạ dày Tá tràng Ruột non Đại tràng Trực tràng
Vị trí khác: ..................................................................................................
- Tình chất: Tăng tín hiệu Giảm Đồng Hỗn hợp
- Huyết khối tĩnh mạch cửa: Không Có
- Hạch ổ bụng: Không Có
- Các bất thường khác:………………...........................................................................
D8. PET-CT: Không Có phát hiện u Có phát hiện u Mô tả: …………………………………………………………………………….......
D9. Sinh thiết / CĐHA: Không Có Kết quả: …..……………………………...
D10. Thăm dò khác (ghi rõ):……………………………………………………………….
E. CHẨN ĐOÁN
E1. Chẩn đoán trước mổ: .........................................................................................………
E2. Chẩn đoán sau mổ: .......................................................................................…………..
F. CÁCH THỨC PHẪU THUẬT Phiên Cấp cứu
PTV:………………………..
F1. Dịch: Không ít vừa nhiều Không mô tả
F2. Di căn phúc mạc: Có Không Không mô tả F3. Di căn gan: Có Không Không mô tả F4. Di căn chỗ khác: Có .................................. Không
F5. Hạch ổ bụng: Có Không Không mô tả
F6. Vị trí u, kích thước u tương ứng:
Thực quản: 1/3 trên...................... 1/3 giữa............................. 1/3 dưới.............................
Dạ dày: Tâm vị............... Hang vị............... Phình vị................. môn vị ................
BCL................... BCN......................
Tá tràng: D........... .....................
Hỗng tràng..................... Hồi tràng...........................
Đại tràng: Manh tràng.......... ĐT lên............ ĐT ngang.......... ĐT xuống............
ĐT Singma............... ĐT phải................ ĐT trái................
Trực tràng.......... Hậu môn .......... Vị trí khác:..........................................................
F7. Màu sắc u: Trắng hồng / trắng vàng Nâu đỏ hồng, xám
F8. Loại phẫu thuật:
Mổ Nội Soi Mổ mở Nội Soi chuyển mở Nội soi hỗ trợ
Thăm dò sinh thiết Mở thông hoặc nối tắt (không cắt được u)
Cắt hình chêm Cắt u tại chỗ (qua đường hậu môn, trực tràng)
Cắt ÔTH kèm u: Lập lại tiêu hóa ngay Đưa ra ngoài làm HMNT. Cắt cụt TT
1 vị trí 2 vị trí 3 vị trí 4 vị trí 5 vị trí
Cụ thể: Thực quản Dạ dày Tá tràng Hỗng tràng Hồi tràng Manh tràng
ĐT lên ĐT ngang ĐT xuống ĐT Singma ĐT phải ĐT trái
Trực tràng Hậu môn Khác: ............................................................................
F9. Nạo vét hạch: Có Không
F10. Khác: …………........................................................................................................
.................................................................................................................................................. G. GIẢI PHẪU BỆNH: Số: ……………… ICD-10: ………….. ICD-0: …… HÌNH ẢNH ĐẠI THỂ
G1. Số lượng u: (ghi rõ số lượng u) ………………………………………………....
Phân loại số lượng u 1 u 2 – 3 u > 3 u
G2. Vị trí và kích thước u tương ứng (mm):
Thực quản: 1/3 trên...................... 1/3 giữa............................. dưới..................................
Dạ dày: Tâm vị............. Phình vị.............. Hang vị............... môn vị .................
BCL................... BCN......................
Tá tràng: D(1-4) ........... .....................
Hỗng tràng..................... Hồi tràng...........................
Đại tràng: ĐT lên........... ĐT ngang............ ĐT xuống............ ĐT Singma...............
ĐT phải................ ĐT trái................
Trực tràng............... Hậu môn .................... Vị trí
khác:.........................................
G3. Mật độ u: Chắc dai Mềm bở Hỗn hợp Không mô tả
G4. Hình dạng u: Cầu, khối, polyp, múi Dẹt, mảng, thâm nhiễm Không mô tả G5. Vỏ, ranh giới: Có Không/Xâm nhập lan tỏa Không mô tả G6. Màu sắc u: Trắng hồng / trắng vàng Nâu đỏ hồng, xám Không mô tả KẾT QUẢ VI THỂ
G7. Chẩn đoán xác định bệnh (chẩn đoán tế bào)
U lympho U Cơ trơn U Cơ vân U GIST U hạt U mỡ
U mạch U hắc tố U bao thần kinh U Kaposi U cuộn mạch
Nghi ngờ: …………………………………………………………………………………...
HÓA MÔ MIỄN DỊCH
G8. Hóa mô miễn dịch: Có làm Không cần làm Có CĐ, cần làm, nhưng chưa làm Loại Marker: ......................................................................................................................
Kết quả: ............................................................................................................................
G9. Nghi ngờ chẩn đoán phân biệt: .....................................................................................
H. THEO DÕI SAU MỔ
H1. Kết quả chung: Tử vong, nặng về Tốt ra viện
H2. Mổ lại Không Có: (do: …………………………)
H3. Biến chứng sớm: Không Có
Nhiễm trùng vết mổ Tràn dịch màng phổi Áp xe tồn dư Viêm phúc mạc
Nhiễm khuẩn tiết niệu Bục rò miệng nối Viêm phổi Chảy máu sau mổ
Suy đa tạng Bí đái
H4. Theo dõi xa (đánh giá tại thời điểm kết thúc nghiên cứu)
Chết Ngày: ......../......../.............
Sống có tái phát bệnh
Sống không có bệnh
Phương thức ghi nhận: Điện thoại phóng vấn. Ngày gọi :...................../Gặp:..................... Điều trị bổ trợ sau mổ: Không Có
Hóa chất Xạ trị Hóa xạ trị Điều trị đích Điều trị miễn dịch Khác: …………………………………………………………………………….....
Thời gian sống sau mổ: …………(tháng)
Phụ Lục 2
HÌNH ẢNH VI THỂ VÀ HÓA MÔ MIỄN DỊCH
07 LOẠI UNG THƯ ÔTH KHÔNG THUỘC BIỂU MÔ
1. U cơ vân ác tính (Rbahdomyosarcoma) (Bệnh nhân: Phạm Văn T.)
| |
HE x 100: Các tế bào u hình thoi, sắp xếp thành bó | HE x 400: Bào tương tế bào u băt màu hồng, nhân lớn, rõ hạt nhân, nhiều nhân chia |
|
|
DESMIN: Dương tính với bào tương tế bào u | MYOGLOBIN: Dương tính dạng hạt với bào tương tế bào u |
|
|
SMA: Âm tính với tế bào u | DOG 1: Âm tính với tế bào u |
Có thể bạn quan tâm!
-
Nghiên cứu đặc điểm lâm sàng, giải phẫu bệnh và kết quả điều trị ung thư ống tiêu hóa không thuộc biểu mô tại bệnh viện Việt Đức - 19 -
Nghiên cứu đặc điểm lâm sàng, giải phẫu bệnh và kết quả điều trị ung thư ống tiêu hóa không thuộc biểu mô tại bệnh viện Việt Đức - 20 -
Nghiên cứu đặc điểm lâm sàng, giải phẫu bệnh và kết quả điều trị ung thư ống tiêu hóa không thuộc biểu mô tại bệnh viện Việt Đức - 21 -
Nghiên cứu đặc điểm lâm sàng, giải phẫu bệnh và kết quả điều trị ung thư ống tiêu hóa không thuộc biểu mô tại bệnh viện Việt Đức - 23 -
Nghiên cứu đặc điểm lâm sàng, giải phẫu bệnh và kết quả điều trị ung thư ống tiêu hóa không thuộc biểu mô tại bệnh viện Việt Đức - 24 -
Nghiên cứu đặc điểm lâm sàng, giải phẫu bệnh và kết quả điều trị ung thư ống tiêu hóa không thuộc biểu mô tại bệnh viện Việt Đức - 25
Xem toàn bộ 205 trang tài liệu này.
2. U mỡ ác tính (Liposarcoma) (Bệnh nhân : Phạm Trọng C.)
| |
HE x 100: Thành phần u biệt hóa cao với các tế bào u có không bào rộng, nhân ở rìa bào tương | HE x 100: Thành phần u mất biệt hóa với các tế bào u hình thoi, nhân bầu |
|
|
HE x 100: Thành phần u mất biệt hóa với các tế bào u hình thoi, nhân bầu | HE x 400: U giàu nhân chia |
3. U mạch máu ác tính (Angiosarcoma) (Bệnh nhân : Nguyễn Văn M.)
| |
HE x 100: Các tế bào u dạng biểu mô, xen kẽ là các mạch máu | HE x 100: Các tế bào u dạng biểu mô, xen kẽ là các mạch máu |
|
|
HE x 100: Các tế bào u dạng biểu mô, xen kẽ là các mạch máu | HE x 400: Rõ hạt nhân, màng nhân méo mó, giàu nhân chia |
|
|
HE x 400: Rõ hạt nhân, màng nhân méo mó, giàu nhân chia | HE x 400: Rõ hạt nhân, màng nhân méo mó, giàu nhân chia |
4. U mô đệm dạ dày ruột (GIST) (Bệnh nhân: Nguyễn Thị L.)
| |
HE x 100: Tế bào u hình thoi nhân bầu, sắp xếp thành bó | HE x 400: Tế bào u hình thoi, nhân bầu sắp xếp thành bó. |
|
|
DOG1: Dương tính mạnh với nhân và bào tương | CD117: Dương tính với bào tương |
|
|
S100: Âm tính với tế bào u, dương tính với chứng nội. | SMA: Âm tính với tế bào u, dương tính với chứng nội. |